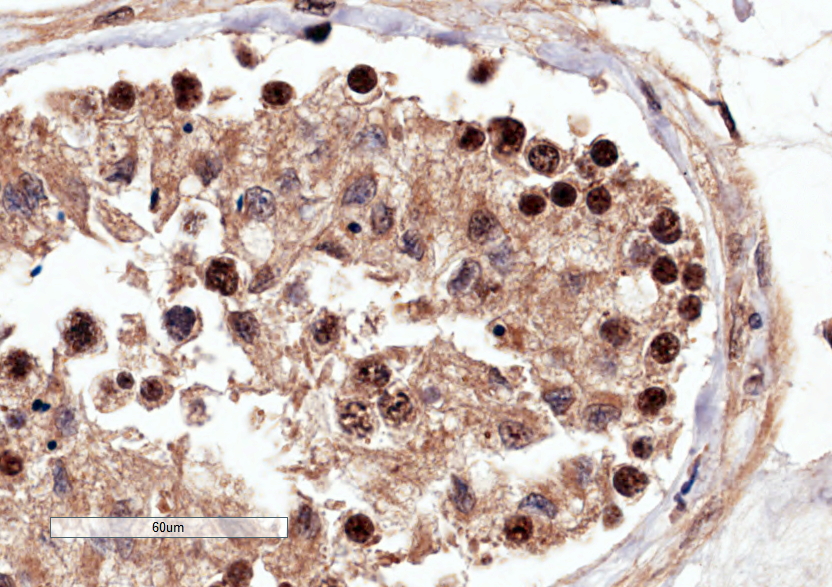

Formulation Supplied at 0.5 mg/ml in Tris saline, 0.02% sodium azide, pH7.3 with 0.5% bovine serum albumin.
| |
Unit Size 100 µg | |
Storage Instructions Aliquot and store at -20°C. Minimize freezing and thawing. | |
Synonym / Alias Names HsCYK-4|HsCYK-4|GTPase activating protein|MGCRACGAP|ID-GAP|Rac GTPase activating protein 1|MgcRacGAP|RACGAP1 | |
Usage Summary Immunofluorescence: Strong expression of the protein seen in the cytoplasm of MCF7 cells. Recommended concentration: 10µg/ml.
Flow Cytometry: Flow cytometric analysis of MCF7 cells. Recommended concentration: 10ug/ml. | |
Accession ID NP_037409.2; NP_001306934.1; NP_001306935.1; NP_001306936.1 | |
Blocking Peptide EBP05315 | |
Immunogen Peptide with sequence C-GRQGNFFASPMLK, from the C Terminus of the protein sequence according to NP_037409.2; NP_001306934.1; NP_001306935.1; NP_001306936.1. | |
Product Comments This antibody is expected to recognize all reported isoforms (NP_037409.2; NP_001306934.1; NP_001306935.1; NP_001306936.1). Reported variants represent identical protein: NP_001306928.1, NP_001119576.1, NP_037409.2, NP_001306931.1, NP_001306929.1, NP_001119575.1, NP_001306932.1, NP_001306930.1, NP_001306933.1 | |
Peptide Sequence C-GRQGNFFASPMLK | |
Purification Method Purified from goat serum by ammonium sulphate precipitation followed by antigen affinity chromatography using the immunizing peptide. | |
Shipping Instructions Refrigerated | |
Predicted Species Human, Dog, Cow | |
Reactive Species Human | |
Human Gene ID 29127 | |
Product Grade ![]() | |
IHC Results In paraffin embedded Human Testis, shows nuclear staining of many cells. Recommended concentration: 1µg/ml. | |
ELISA Detection Limit Antibody detection limit dilution 1:32000. | |
Western Blot Approx 75kDa band observed in lysates of cell line Jurkat, and in nuclear lysates of cell lines A431 and Jurkat (calculated MW of 71.0kDa according to NP_037409.2). Recommended concentration: 0.3-1µg/ml. Primary incubation 1 hour at room temperature. Negative Control: Human Pancreas lysate. | |
Application Type Pep-ELISA, WB, IHC, IF, FC |
Goat Anti-RACGAP1 / MgcRacGAP Antibody
$464.00
| SKU | Unit Size | Price |
|---|---|---|
Select a unit size:
Documents |